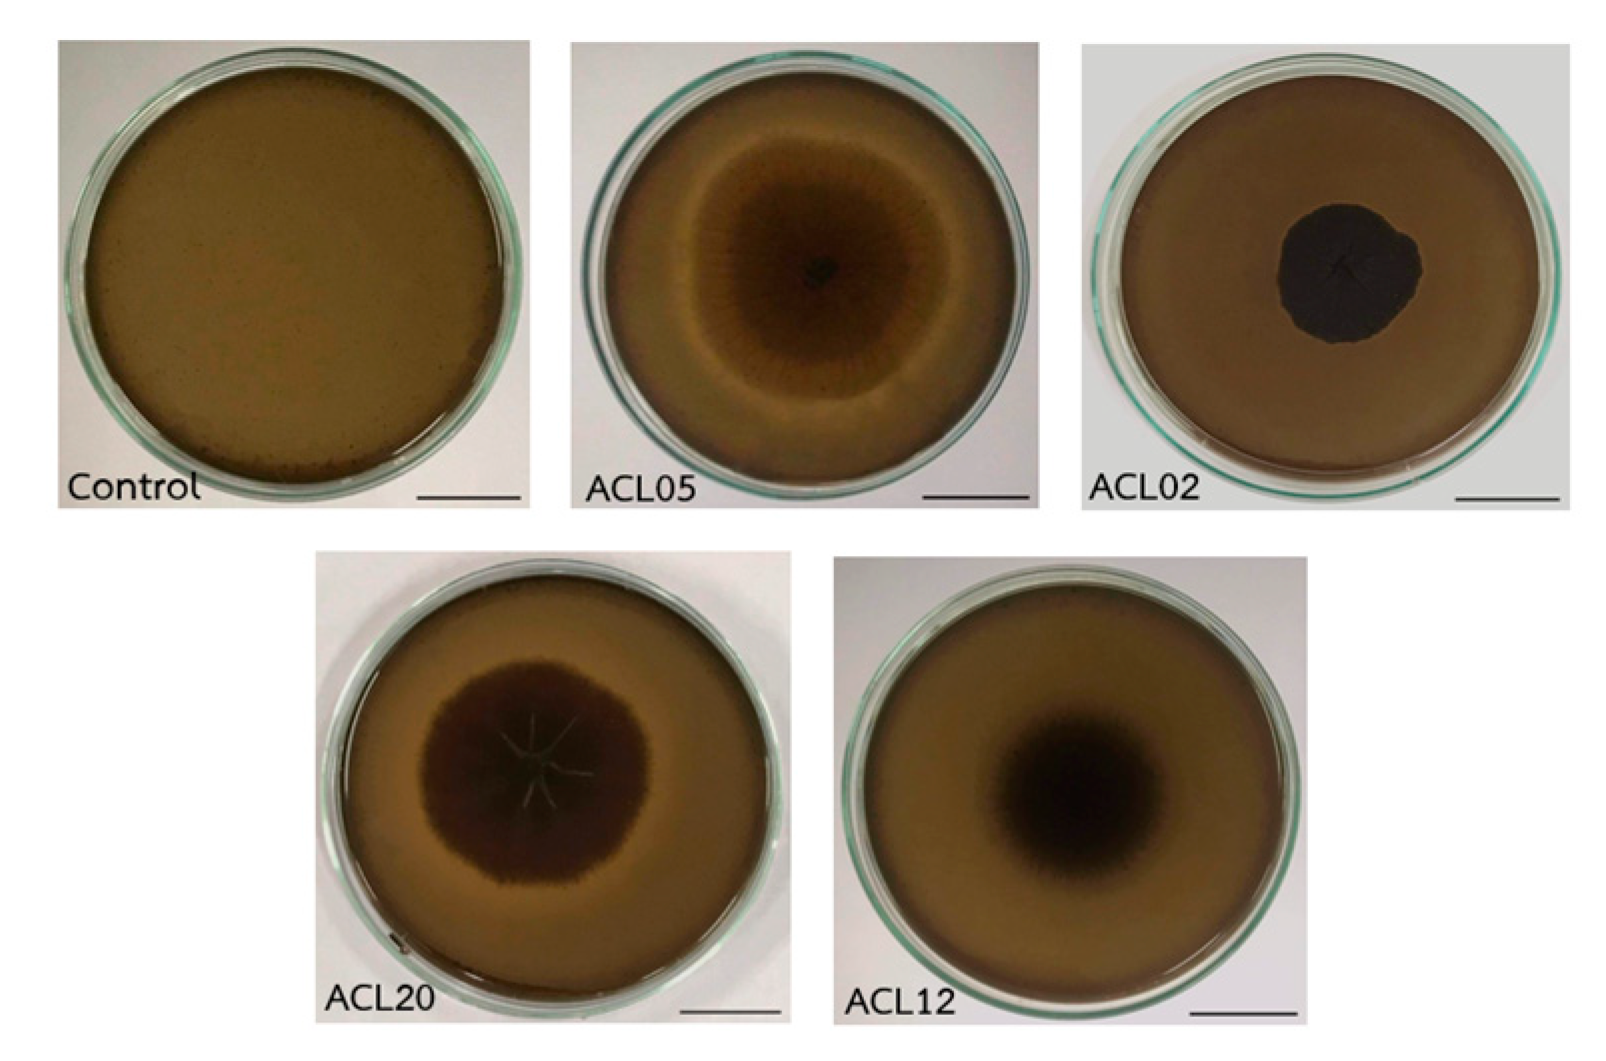
Preprints 194112 g002
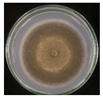
Preprints 194112 i001
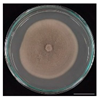
Preprints 194112 i002
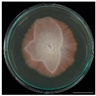
Preprints 194112 i003
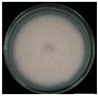
Preprints 194112 i004
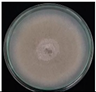
Preprints 194112 i005

Submitted:
13 January 2026
Posted:
14 January 2026
You are already at the latest version
Abstract
Melanin accumulation is the primary cause of skin hyperpigmentation, and most existing cosmetic agents address this process by inhibiting melanogenesis. In contrast, strategies that directly decolorize or degrade melanin remain largely unexplored. In this study, we report a novel biobased cosmetic ingredient derived from onion (Allium cepa)–associated endophytic fungi that exhibits direct melanin decolorization alongside skin-whitening and anti-aging activities. Endophytic fungi were isolated from onion tissues, and aqueous extracts were prepared to ensure cosmetic-grade compatibility. Preliminary screening demonstrated exceptional melanin-reducing capacity among the isolates, with a maximum reduction of 97.83%, highlighting their strong melanin degrading potential. A selected isolate, identified as Aspergillus brasiliensis (ACL05), was further investigated to elucidate the influence of sterilization methods on bioactivity. The autoclaved culture filtrate retained substantial melanin-reducing activity (62.85%), whereas ultrasonication-based cell inactivation resulted in significantly lower activity (32.54%), indicating that heat-stable extracellular metabolites are primarily responsible for melanin decolorization. A cosmetic essence formulated using the sterile ACL05 extract achieved a measurable melanin reduction of 15.39%, demonstrating formulation feasibility and functional efficacy. Beyond melanin decolorization, the ACL05 extract exhibited multifunctional anti-aging properties, including inhibitory activities against tyrosinase, collagenase, and elastase, as well as significant antioxidant capacity as determined by the DPPH assay. Collectively, these findings reveal, for the first time, the potential of onion-derived endophytic Aspergillus brasiliensis as a sustainable source of multifunctional cosmetic bioactives. This work introduces a new paradigm for skin-whitening based on direct melanin decolorization while simultaneously addressing skin aging, supporting the development of next-generation biobased cosmetic ingredients.
Keywords:
1. Introduction
2. Materials and Method
2.1. Sample Collection and Isolation of Endophytic Fungi
2.2. Efficacy Testing of Endophyte Extracts on Melanin Content
2.3. Effect of Sterilization on the Melanin Decolorization Activity
2.4. Screening and Identification of the Endophytic Fungi
2.5. Preparation for Endophytic Fungal Extract
2.6. Experimental Design of Antioxidant Activity Assay (DPPH Free Radical Scavenging Assay)
2.7. In Vitro Antiaging Assays
2.7.1. Anti-Collagenase Assay
2.7.2. Anti- Elastase Assay
2.7.3. Anti- Tyrosinase Assay
2.8. Development of a Facial Essence Containing Selected Endophyte Fungal Culture Media to Test Its Melanin-Reducing Efficacy
2.9. Stability Testing of the Endophyte Fungal Culture Essence Product Under accelerated Conditions
3. Results
3.1. Sample Collection and Isolation of Endophytic Fungi
3.2. Efficacy Testing of Endophyte Extracts on Melanin Content
3.3. Effect of Sterilization on the Melanin Decolorization Activity
3.4. The effectiveness of PDB from ACL05 in reducing melanin by ultrasonic
3.5. Screening and Identification of the Endophytic Fungi
3.6. Experimental Design of Antioxidant Activity Assay
3.7. Formulation of Topical Essence Containing Melanin-Reducing Endophytic Extract
| Round | Physical characteristics | ||||
| Color | odor | Separation of layers | viscosity | pH | |
| 0 | light green | aloe vera | Not separate | ++ | 5.5 |
| 3 | light green | aloe vera | Not separate | + | 5.5 |
| 6 | light green | aloe vera | Not separate | + | 5.5 |
| Round | Physical characteristics | ||||
| Color | odor | Separation of layers | viscosity | pH | |
| 0 | light green | aloe vera | Not separate | ++ | 5.5 |
| 3 | light green | aloe vera | Not separate | ++ | 5.5 |
| 6 | light green | aloe vera | Not separate | ++ | 5.5 |
4. Discussion
5. Conclusions
Author Contributions
Funding
Institutional Review Board Statement
Informed Consent Statement
Data Availability Statement
Acknowledgments
Conflicts of Interest
References
- Promputtha, I.; Jeewon, R.; Lumyong, S.; Mckenzie, E.; Hyde, K.D. Ribosomal DNA Fingerprinting in the Identification of Non Sporulating Endophytes from Magnolia liliifera (Magnoliaceae). Fungal Divers. 2005, 20, 167–186. [Google Scholar]
- Aly, A.H.; Debbab, A.; Kjer, J.; Proksch, P. Fungal Endophytes from Higher Plants: A Prolific Source of Phytochemicals and Other Bioactive Natural Products. Fungal Divers. 2010, 41, 1–16. [Google Scholar] [CrossRef]
- Ruma, K.; Sunil, K.; Prakash, H.S. Antioxidant, Anti-Inflammatory, Antimicrobial and Cytotoxic Properties of Fungal Endophytes from Garcinia Species. Int. J. Pharm. Pharm. Sci. 2013, 5. [Google Scholar]
- Cui, J.-L.; Guo, T.-T.; Ren, Z.-X.; Zhang, N.-S.; Wang, M.-L. Diversity and Antioxidant Activity of Culturable Endophytic Fungi from Alpine Plants of Rhodiola crenulata, R. angusta, and R. sachalinensis. PLoS ONE 2015, 10, e0118204. [Google Scholar] [CrossRef]
- Chandra, H.; Yadav, A.; Prasad, R.; Kalra, S.J.S.; Singh, A.; Bhardwaj, N.; Gupta, K.K. Fungal Endophytes from Medicinal Plants Acting as Natural Therapeutic Reservoir. Microbe 2024, 3, 100073. [Google Scholar] [CrossRef]
- Vishwakarma, S.; Chaudhry, V.; Chand, S.; Sagar, K.; et al. The potential of fungal endophytes in plants: Sources of bioactive compounds. Indian Journal of Microbiology 2024, 65, 1–15. [Google Scholar] [CrossRef]
- Yousef, H.; Alhajj, M.; Fakoya, A.O.; Sharma, S. Anatomy, Skin (Integument), Epidermis. In StatPearls; StatPearls Publishing: Treasure Island (FL), 2025. [Google Scholar]
- Michalak, M.; Pierzak, M.; Kręcisz, B.; Suliga, E. Bioactive Compounds for Skin Health: A Review. Nutrients 2021, 13, 203. [Google Scholar] [CrossRef]
- Mostert, A.B. Melanin, the What, the Why and the How: An Introductory Review for Materials Scientists Interested in Flexible and Versatile Polymers. Polymers 2021, 13, 1670. [Google Scholar] [CrossRef]
- Langfelder, K.; Streibel, M.; Jahn, B.; Haase, G.; Brakhage, A.A. Biosynthesis of Fungal Melanins and Their Importance for Human Pathogenic Fungi. Fungal Genet. Biol. 2003, 38, 143–158. [Google Scholar] [CrossRef]
- Marino, S.M.; Fogal, S.; Bisagilia, M.; Moro, S.; Scartabelli, G.; Gioia, L.D.; Spada, A.; Monzani, E.; Casella, L.; Mammi, S.; Bubacco, L. Investigation of Streptomycesantibioticus Tyrosinase Reactivity toward Chlorophenols. Arch Biochem Biophys 2011, 505, 67–74. [Google Scholar] [CrossRef]
- Rusu, A.; Farcaș, A.-M.; Oancea, O.-L.; Tanase, C. Cannabidiol in Skin Health: A Comprehensive Review of Topical Applications in Dermatology and Cosmetic Science. Biomolecules 2025, 15, 1219. [Google Scholar] [CrossRef]
- Saeedi, M.; Eslamifar, M.; Khezri, K. Kojic Acid Applications in Cosmetic and Pharmaceutical Preparations. Biomed. Pharmacother. 2019, 110, 582–593. [Google Scholar] [CrossRef] [PubMed]
- Chauhan, L.; Gupta, S. Creams: A review on classification, preparation methods, evaluation and its applications. Journal of Drug Delivery and Therapeutics 2020, 10, 281–289. [Google Scholar] [CrossRef]
- Sahu, P.K.; Tilgam, J.; Mishra, S.; Hamid, S.; Gupta, A.; K, J.; Verma, S.K.; Kharwar, R.N. Surface Sterilization for Isolation of Endophytes: Ensuring What (Not) to Grow. J. Basic Microbiol. 2022, 62, 647–668. [Google Scholar] [CrossRef]
- Huang, X.; Yang, N.; Cao, M.; Sun, H. Lycium chinense root supercritical fluid extract inhibits melanogenesis by down-regulating tyrosinase activity, tyrosinase-related proteins, and microphthalmia-associated transcription factor in B16F10 melanoma cells. BMC Complementary and Alternative Medicine 2014, 14, 208. [Google Scholar]
- Suwannarach, N.; Kumla, J.; Nishizaki, Y.; Sugimoto, N.; Meerak, J.; Matsui, K.; Lumyong, S. Optimization and Characterization of Red Pigment Production from an Endophytic Fungus, Nigrospora aurantiaca CMU-ZY2045, and Its Potential Source of Natural Dye for Use in Textile Dyeing. Appl. Microbiol. Biotechnol. 2019, 103, 6973–6987. [Google Scholar] [CrossRef]
- Zhao, J.T.; Fu, Y.J.; Luo, M.; Zu, Y.G.; Wang, W.; et al. Endophytic fungi from pigeon pea [Cajanus cajan (L.) Mill sp.] produce antioxidant cajaninstilbene acid. J Agr Food Chem 2012, 60, 4314–4319. [Google Scholar] [CrossRef] [PubMed]
- Thring, T.S.A.; Hili, P.; Naughton, D.P. Anti-Collagenase, Anti-Elastase and Anti-Oxidant Activities of Extracts from 21 Plants. BMC Complement. Altern. Med. 2009, 9. [Google Scholar] [CrossRef]
- Kim, Y.-J.; Uyama, H.; Kobayashi, S. Inhibition Effects of (+)-Catechin–Aldehyde Polycondensates on Proteinases Causing Proteolytic Degradation of Extracellular Matrix. Biochem. Biophys. Res. Commun. 2004, 320, 256–261. [Google Scholar] [CrossRef]
- Batubara, I.; Darusman, L.K.; Mitsunaga, T.; Rahminiwati, M.; Djauhari, E. Potency of Indonesian medicinal plants as tyrosinase inhibitor and antioxidant agent. J. Biol. Sci. 2010, 10, 138–144. [Google Scholar] [CrossRef]
- Schulz, B.; Boyle, C.; Draeger, S.; Römmer t, A.-K.; Krohn, K. Endophytic fungi: A source of novel biologically active secondary metabolites. Mycological Research 2002, 106, 996–1004. [Google Scholar] [CrossRef]
- Sadagat, B.; Khatoon, N.; Malik, A.Y.; Jamal, A.; Farooq, U.; Ali, M.I.; He, H.; Liu, F.-J.; Guo, H.; Urynowicz, W.; Wang, Q.; Huang, Z. Enzymatic Decolonization of Melanin by Lignin Peroxidase from Phanerochaete Chrysosporium. Sci Rep 2020, 10, 20240. [Google Scholar] [CrossRef]
- Strobel, G.A.; Daisy, B. Bioprospecting for microbial endophytes and their natural products. Microbiology and Molecular Biology Reviews 2003, 67, 491–502. [Google Scholar] [CrossRef] [PubMed]
- Tan, R.X.; Zou, W.X. Endophytes: A rich source of functional metabolites. Natural Product Reports 2001, 18, 448–459. [Google Scholar] [CrossRef] [PubMed]
- Tejesvi, M.V.; Kini, K.R.; Prakash, H.S.; Ven, S.; Shetty, H.S. Genetic diversity and antifungal activity of species of Pestalotiopsis isolated as endophytes from medicinal plants. Fungal Diversity 2007, 24, 37–54. [Google Scholar]
- Ruma, K.; Shailasree, S.; Sampath, K.K.; Niranjana, S.R.; Prakash, H.S. Endophytic fungal assemblages in Calophyllum and Garcinia spp. (Clusiaceae) in the Western Ghats, India. Current Biotechnology 2016, 1, 99–108. [Google Scholar] [CrossRef]
- Phongpaichit, S.; Nikom, J.; Rungjindamai, N.; Sakayaroj, J.; Hutadilok-Towatana, N.; Rukachaisirikul, V.; Kirtikara, K. Biological activities of extracts from endophytic fungi isolated from Garcinia plants. FEMS Immunology and Medical Microbiology 2007, 51, 517–525. [Google Scholar] [CrossRef]
- Davis, J.; López, L. Tissue-specific diversity of fungal endophytes isolated from Solanaceae crops. Journal of Mycology and Plant Pathology 2021, 51, 307–319. [Google Scholar]
- Goralski, K.B.; Hammel, K.E. *Enzymatic decolorization of melanin by lignin peroxidase from Phanerochaete chrysosporium. Scientific Reports 2020, 10, 1–10. [Google Scholar] [CrossRef]
- Shin, S.; Hyoen, J.; Joo, Y.; Jeong, S.; You, S.; Han, S. Effective melanin degradation by a synergistic laccase-peroxidase enzyme complex for skin whitening and other practical applications. Int J Biol Macromol. 2019, 129, 181–186. [Google Scholar] [CrossRef]
- Nagasaki, K.; Kumazawa, M.; Murakami, S.; Takenaka, S.; Koike, K.; Aoki, K. Purification, characterization, and gene cloning of Ceriporiopsis sp. Strain MD-1 peroxidases that decolorize human hair melanin. Appl Environ Microbiol. 2008, 74, 5106–5112. [Google Scholar] [CrossRef] [PubMed]
- Lumyong, S.; Lumyong, P.; McKenzie, E.H.C.; Hyde, K.D. Enzymatic Activity of Endophytic Fungi of Six Native Seedling Species from Doi Suthep-Pui National Park, Thailand. Can. J. Microbiol. 2002, 48, 1109–1112. [Google Scholar] [CrossRef] [PubMed]
- Promputtha, I; Lumyong, S; Dhanasekaran, V; McKenzie, EHC; Hyde, KD; Jeewon, R. A Phylogenetic Evaluation of Whether Endophytes. 2007. [Google Scholar] [CrossRef]
- Yu, J.; Cai, J. Enzymatic decolorization of melanin by lignin peroxidase from Phanerochaete chrysosporium: Effects of pH and temperature. Scientific Reports 2020, 10, 76376. [Google Scholar] [CrossRef]
- Sahadevan, L.M.; Misra, C.S.; Thankamani, V. Characterization of lignin degrading enzymes (LDEs) from a dimorphic novel fungus and identification of products of enzymatic breakdown of lignin. 3 Biotech. 2016, 6, 56. [Google Scholar] [CrossRef]
- Rohn, S.; Buchner, N.; Driemel, G.; Rauser, M.; Kroh, L.M. Thermal degradation of onion quercetin glucosidase under roasting conditions. J. Agric. Food Chem. 2007, 55, 1568–1573. [Google Scholar] [CrossRef]
- Burge, H. How dose heat affect fungi? FEMS Microbial Ecol. 2006, 3, 49–58. [Google Scholar]
- Mohammad, H.D.; Amir, H.M.; Gholam, R.J.; Razieh, S. Investigation and Evaluation of Ultrasound Reactor for Reduction of Fungi from Sewage. J. Zhejiang Univ. Sci. B 2007, 8, 493–497. [Google Scholar] [CrossRef]
- Zhu, Z.; Zhu, W.; Yi, J.; Liu, N.; Cao, Y.; Lu, J.; Decker, E.A.; McClements, D.J. Effects of Sonication on the Physicochemical and Functional Properties of Walnut Protein Isolate. Food Res. Int. 2018, 106, 853–861. [Google Scholar] [CrossRef]
- Özbek, B.; Ülgen, K.Ö. The Stability of Enzymes after Sonication. Process Biochem. 2000, 35, 1037–1043. [Google Scholar] [CrossRef]
- Jiang, Q.; Han, J.; Gao, P.; Yu, L.; Xu, Y.; Xia, W. Effect of Heating Temperature and Duration on the Texture and Protein Composition of Bighead Carp (Aristichthys nobilis) muscle. Int. J. Food Prop. 2018, 21, 2110–2120. [Google Scholar] [CrossRef]
- Seifried, H.E.; Anderson, D.E.; Fisher, E.I.; Milner, J.A. A review of the interaction among dietary antioxidants and reactive oxygen species. J Nutr Biochem. 2007, 18, 567–579. [Google Scholar] [CrossRef] [PubMed]

| Order | Endophytic fungal isolates | % Melanin decolorization (%MDC) |
| 1 | LEL01 | 15.64 ±0.0224 |
| 2 | LEL02 | 8.01±0.00550 |
| 3 | LEL03 | 24.42±0.0096 |
| 4 | LEL04 | 3.62±0.0229 |
| 5 | LEL05 | 15.45±0.0098 |
| 6 | LEL06 | 20.03±0.0186 |
| 7 | LEL07 | 9.92±0.0165 |
| 8 | LEL08 | 2.09±0.0110 |
| 9 | LEL09 | 36.83±0.0140 |
| 10 | LEL10 | ND |
| 11 | LES01 | ND |
| 12 | LES02 | 5.53±0.0090 |
| 13 | LES03 | ND |
| 14 | LES04 | ND |
| 15 | LES05 | ND |
| 16 | LES06 | ND |
| 17 | LES07 | ND |
| 18 | LES08 | 19.65±0.0135 |
| 19 | ACL01 | 11.06±0.0252 |
| 20 | ACL02 | 57.44±0.0045 |
| 21 | ACL03 | ND |
| 22 | ACL04 | 7.44±0.0061 |
| 23 | ACL05 | 76.52±0.0058 |
| 24 | ACL06 | 26.90±0.0136 |
| 25 | ACL07 | 19.08±0.0090 |
| 26 | ACL08 | ND |
| 27 | ACL09 | 30.15±0.0105 |
| 28 | ACL10 | 14.31±0.0055 |
| 29 | ACL11 | 14.12±0.0030 |
| 30 | ACL12 | 40.07±0.0020 |
| 31 | ACL13 | 13.16±0.0041 |
| 32 | ACL14 | 32.82±0.0134 |
| 33 | ACL15 | 29.19±0.0132 |
| 34 | ACL16 | 29.96±0.0045 |
| 35 | ACL17 | ND |
| 36 | ACL18 | 1.90±0.0070 |
| 37 | ACL19 | 32.63±0.0045 |
| 38 | ACL20 | 45.99±0.0030 |
| Fungal isolate code | Colony characteristics | |
| ACL05 | ![]() |
Colony green to dark, white colony with the entire edge Dense mycelium |
| ACL02 | ![]() |
Colony green to grey, circular with the entire edge, rounded in shape, slightly convex in the middle, smooth edges, hard surface |
| ACL20 | ![]() |
Colony red orange circular with the entire edge, rounded in shape, white convex in the middle, rough edges, hard surface |
| ACL12 | ![]() |
Colony white, dense mycelium with filiform margin |
| LEL09 | ![]() |
Colony green to grey, white colony with the entire edge Dense mycelium with filiform margin |
| Fungal isolation code | Melanin Light absorption at 280 nanometer | % MDC |
| ACL20 | 0.005±0.0119a | 99.09±0.011 |
| ACL05 | 0.012±0.0162a | 97.83±0.016 |
| ACL12 | 0.069±0.0055b | 87.31±0.005 |
| ACL02 | 0.295±0.0205c | 46.75±0.020 |
| Days | Melanin absorbance (A280 nm) | % MDC |
| Control | 0.522±0.0005a | 0.52±0.001 |
| 0 | 0.521±0.0010 | 0.19±0.001 |
| 1 | 0.521±0.0010 | 0.19±0.001 |
| 2 | 0.520±0.0011 | 0.38±0.00 |
| 3 | 0.520±0.0005 | 0.38±0.001 |
| 4 | 0.519±0.0001 | 0.57±0.000 |
| 5 | 0.519±0.0005 | 0.57±0.001 |
| 6 | 0.519±0.0015 | 0.57±0.001 |
| 7 | 0.519±0.0015a | 0.57±0.001 |
| Gene Locus | Closest Match | NCBI Accession Number | Similarity |
| ITS | Aspergillus brasiliensis | MH862749 | 100% |
| LSU | Aspergillus brasiliensis | NG069859 | 100% |
| BenA | Aspergillus brasiliensis | FJ629272 | 100% |
| CaM | Aspergillus brasiliensis | FN594543 | 100% |
| RPB2 | Aspergillus brasiliensis | KY006765 | 100% |
| Tef1-α | Aspergillus brasiliensis | FN665411 | 100% |
| Tests | Half maximal inhibitory concentration (IC50: mg/ml) | |
| ACL05 | Standard compounds | |
| 1,1-diphenyl-2-picrylhydrazyl | ||
| (DPPH inhibition) | 5.21±1.85 | Gallic acid 0.08±2.25 |
| Anti-collagenase | 113.63±3.85 | EGCG 67.8±2.85 |
| Anti-elastase | 8.33±4.25 | EGCG 10.2±2.52 |
| Anti-tyrosinase | 37.31±2.59 | Koji acid 29.1±1.85 |
Disclaimer/Publisher’s Note: The statements, opinions and data contained in all publications are solely those of the individual author(s) and contributor(s) and not of MDPI and/or the editor(s). MDPI and/or the editor(s) disclaim responsibility for any injury to people or property resulting from any ideas, methods, instructions or products referred to in the content. |
© 2026 by the authors. Licensee MDPI, Basel, Switzerland. This article is an open access article distributed under the terms and conditions of the Creative Commons Attribution (CC BY) license (http://creativecommons.org/licenses/by/4.0/).